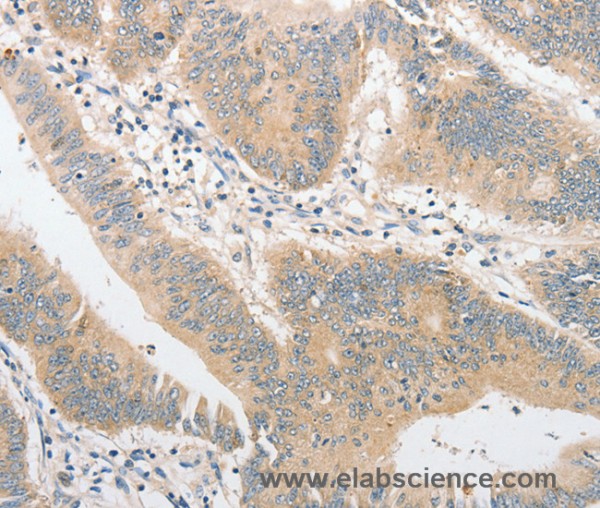
Anti-TLR4

If you have any questions, please use our Contact Form.
You can also order by e-mail: info@biomol.com
Larger quantity required? Request bulk
You can also order by e-mail: info@biomol.com
Larger quantity required? Request bulk
Viewed
| Keywords: | Anti-TLR4, Anti-CD284, Anti-hToll, Anti-Toll-like receptor 4, TLR4 Polyclonal Antibody |
| Supplier: | Elabscience |
| Supplier-Nr: | E-AB-10871 |
Properties
| Application: | IHC, ELISA |
| Antibody Type: | Polyclonal |
| Conjugate: | No |
| Host: | Rabbit |
| Species reactivity: | human |
| Immunogen: | Recombinant protein of human TLR4 |
| Format: | Purified |
Database Information
| KEGG ID : | K10160 | Matching products |
| UniProt ID : | O00206 | Matching products |
| Gene ID : | GeneID 7099 | Matching products |
Handling & Safety
| Storage: | -20°C |
| Shipping: | 4°C (International: -20°C) |
